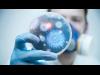

بعد نحو شهر من إطلاق النسخة التجريبية من حزمة Microsoft Office والتي تتألف من التطبيقات Word و Excel و PowerPoint لهواتف الأندرويد، فقد أعلنت شركة مايكروسوفت اليوم
|
تطبيق WhatsApp وما شابهه من تطبيقات المراسلة الفورية تستخدم رقم الهاتف الخاص بك كوسيلة لتسجيل الدخول إلى حسابك. ولكن منذ إصداره لأول مرة كان تطبيق Facebook Messenger
|
بعد حوالي ستة أشهر من إطلاقها حزمة تطبيقات أوفيس للحواسب اللوحية العاملة بنظام أندرويد، أعلنت مايكروسوفت اليوم عن توفّر نفس التطبيقات لهواتف أندرويد.
|
على ما يبدو أن متصفح مايكروسوفت الجديد Edge browser لويندوز 10 موبايل فى طريقه ليصبح تطبيقا، وذلك لكى يعطى مايكروسوفت القدرة على إتاحة التحديثات سريعا من خلال متجر ويندوز فون.
|
أطلقت شركة بوكس إصدارا جديدا من خدمتها خاص بمايكروسوفت أوفيس يدعى Box for Office يسمح لمستخدميها بإنشاء وتعديل مستندات أوفيس من خلال موقع بوكس على المتصفح وذلك حسب ما أعلنت كلا الشركتين.
|
أفادت وكالة الأنباء رويترز في الأونة الأخيرة أن شركة AMD تدرس حاليا خيار تفكيك الشركة أو على الأقل الإنفصال، وقد جاءت هذه الشائعات عدة مرات في الماضي ولكن نظرا لأن هذه الشائعات |
بعد قرابة العام من الإعلان عن لغة تصميم الماتيريال ديزاين من قبل جوجل العام الماضي، وصلت لغة التصميم الجديدة لأغلب التطبيقات، و اليوم دروب بوكس أخر من إعتمد على لغة |
أضافت شركة “جوجل ” ميزة “التراجع عن إرسال Undo Send” رسالة البريد الإلكترونى بعد إرسالها ، و هو ما يتيح لمستخدم بريد ” جيميل Gmail” التابع لها من تدارك ارسال رسالة
|
مع دخولنا الأيام الأولى في شهر رمضان المبارك، يعتزم الكثير من الأشخاص لإتمام ختمة أو أكثر للقرآن الكريم طيلة شهر رمضان، ولكن تنظيم إتمام هذه الختمة
|
بعد أيام قليلة من إصدارها لتطبيق مشاركة الصور Facebook Moments والذي يستطيع التعرف على الأشخاص في الصور بإستخدام تقنية التعرف على الوجوه، قالت شركة الفيسبوك بأن هذا التطبيق لن يكون متاحا في أوروبا.
|
ذكر عدد من مستخدمي هواتف الأندرويد العاملة بنظام الأندرويد 5.1 بأن شريط البحث يقوم بإقتراح عدد من الأوامر الذي من الممكن تنفيذها بواسطة خدمة جوجل ناو. هذه الحركة
|
تعتبر الوسوم أو ما يُعرف بـ الهاشتاج ، أحد أكثر الوسائل المفيدة في تطبيق "إنستجرام" Instagram للوصول إلى معجبين جدد ومُتابعين يمكن لهم أن يعجبوا بما
|
صرح الدكتور أمين لطفي رئيس جامعة بنى سويف بأن الجامعة أطلقت المسابقة الأولى فى الإبداع والابتكار العلمي لمركز تنمية الموهوبين والمبدعين والمبتكرين تحت شعار |
أعلنت شركة آبل مؤخرا أنها بدأت برنامج إستبدال أقراص 3 تيرابايت لبعض حواسيب iMac القديمة بحجم 27 إنش، ويأتي هذا القرار من شركة آبل بعدما تبين للشركة أن أقراص 3 تيرابايت
|
توصل خبراء أمريكيون إلى تقنية جديدة زهيدة الثمن لاختبار الدم، تتيح تحديد كل الإصابات الجرثومية التي أصيب بها الشخص في حياته.
|
إذا قمت بتثبيت ويندوز 10 إصدار “(build 10130)”، ستتمكّن من الحصول على نظام ويندوز 10 النسخة النهائية بإستخدام إيميل إلكتروني لبرنامج “ويندوز إنسايدر” التجريبي ويمكنك البدء بتنفيذ هذه الخطوة الآن.
|
إذا كنت من الأشخاص الذين يعانون من الكسل وتجد صعوبة وملل فى البحث عن ريموت التحكم فى جهاز التليفزيون فقريبا سيكون من الممكن تغيير القنوات
|
شهدت تطبيقات "فيس بوك" و"تويتر" مؤخرًا إطلاق ميزة جديدة، وهى عرض وتشغيل مقاطع الفيديو تلقائيًا دون تدخل من المستخدم، وهو ما يعنى أن
|
بما أن مايكروسوفت تعول كثيراً على متصفح الـ Edge، فمايكروسوفت ستقوم بإضافة خاصية جديدة للمتصفح، و هي إمكانية تحميل الملفات في الخلفية. أحد
|
يُعتبر تطبيق Pushbullet واحدًا من تطبيقات أندرويد الأساسية التي يصعُب الاستغناء عنها في أي هاتف أو حاسب لوحي، حيث وفّر لملايين المُستخدمين طريقة سهلة لنقل الروابط مابين
|
أطلقت شركة بِت تورنت BitTorrent تطبيقها الجديد Shoot الذي يعتمد رمز الاستجابة السريع كذلك، لكن لإرسال الملفّات بسرعة وسهولة بين الهواتف.
|
عندما يتعلق الأمر بعادات التسوق والإنفاق، فهل هناك حقا فرق بين شخص لديه هاتف iPhone وشخص يستخدم هاتف يعمل بنظام الأندرويد؟ حسنا، يبدو أن شبكة MarketWatch المتخصصة
|
أعلنت شركة "فوكالكوم" اليوم عن بناء علاقة استراتيجية مع شركة ن.س.ر لتأمين خدمات مراكز اتصالات قائمة على السحابة متعددة القنوات في الإمارات العربية المتحدة.
|
كشفت شركة مايكروسوفت أنها ستقوم بإحالة النسخة الحديثة من تطبيق Skype لنظام الويندوز إلى التقاعد. وبالنظر إلى أنه إقترب موعد إصدار الويندوز 10 فمن المنطقي لمايكروسوفت
|
أكدت العديد من التقارير تمكن مجموعة من الهاكرز من سرقة بيانات نحو 7 مليون موظف في الحكومة الأمريكية، بعد اختراقهم لموقع الموظفين الفيدراليين وسرقة جميع بياناتهم.
|
تطبيقات الأجهزة الذكية كثيرة، وتختلف في بعض المواصفات من نظام تشغيل لآخر، وأكثر ما يثير بال بعض المستخدمين هو مقارنة واجهات تطبيق محدد بين نظامي تشغيل أندرويد و iOS.
|
الرجوع بالذاكرة في بعض الأحيان يُعيد الكثير من اللحظات المثيرة والمهمة في حياة المستخدم، ومعرفة النفسية والمزاج الذي كان به حينها يُساعده على تحسين نفسيته في الوقت الحالي.
|
أطلقت "أكسيس كوميونيكيشنز" جهاز تحويل الفيديو الجديد M7011 المدمج أحادي القناة ويتيح الجهاز الجديد سهولة وفعالية دمج كاميرات الأنالوج التقليدية مع نظم المراقبة الشبكية
|
أعلنت اليوم كل من "نيوبوي" و"إس إيه بي" و"أم دي ساب"، التوقيع على اتفاقية تحصل الأولى بموجبها على حلّ مبيعات التجزئة "ريتيل" العامل على منصة "هانا" من "إس إيه بي"، |
إن كنت من مستخدمي نظام ماك ولديك آيفون فقد تعجبك هذه الطريقة لتأمين جهازك الماك.
تطبيق Near Lock هو ما تحتاج إليه ويمكنك الوصول له عبر متجر آبل |